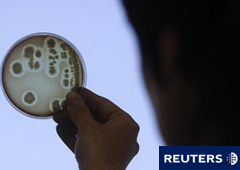
Una única remesa de semillas de alhovas procedente de Egipto es el origen más probable de una altamente tóxica epidemia de E. coli en Alemania que ha matado a 49 personas y de un brote más pequeño en Francia, dijeron el martes investigadores europeos. En

LONDRES (Reuters) – Una única remesa de semillas de alhovas procedente de Egipto es el origen más probable de una altamente tóxica epidemia de E. coli en Alemania que ha matado a 49 personas y de un brote más pequeño en Francia, dijeron el martes investigadores europeos.
La Autoridad Europea de Seguridad Alimentaria (EFSA, por sus siglas en inglés) instó a la Comisión Europea a realizar "todos los esfuerzos" necesarios para evitar cualquier exposición adicional del consumidor a semillas sospechosas y aconsejó a los consumidores que no consumieran brotes o brotes germinados si no estaban cocinados a conciencia.
Más de 4.100 personas en Europa y Norteamérica se han infectado en dos brotes de E. coli, una cuyo foco estuvo en el norte de Alemania y otra alrededor de la ciudad francesa de Burdeos.
Casi todos los afectados en el primer brote – el más mortífero registrado – vivían en Alemania o habían viajado recientemente allí. La infección ha matado a 48 personas en Alemania y a una persona en Suecia hasta ahora.
"El análisis de la información de los brotes francés y alemán lleva a la conclusión de que un lote importado de semillas de alhovas que fue utilizado para cultivar brotes importado desde Egipto por un importador alemán es el vínculo más probable", dijo la EFSA en un comunicado.
Pero añadió que "otros lotes de alhovas importadas desde Egipto durante el período 2009 a 2011 podrían estar implicados" y dijo que deberían llevarse a cabo más investigaciones en todos los países que podrían haber recibido semillas de los lotes afectados.
La cepa de las infecciones por E.coli identificadas en los brotes – conocida como STEC O104:H4 – puede causar una grave diarrea y, en casos graves, fallos renales y la muerte.